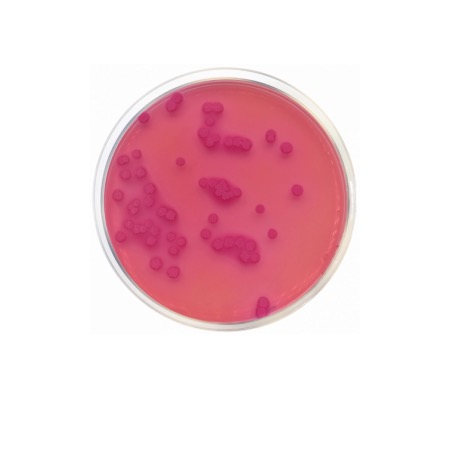

MacConkey Agar EP/USP/ISO is a dehydrated selective and differential medium used for the isolation of Gram-negative enteric bacteria and differentiation of lactose-fermenting and non-lactose-fermenting organisms. The medium complies with EP, USP and ISO requirements and is widely applied in food, pharmaceutical and clinical microbiology.
MacConkey Agar EP/USP/ISO (catalogue No. 1052) is a selective and differential culture medium intended for the isolation of Gram-negative enteric bacteria, particularly members of the family Enterobacteriaceae. The formulation contains bile salts and crystal violet, which inhibit Gram-positive organisms, while lactose and neutral red allow differentiation based on lactose fermentation.
Lactose-fermenting organisms produce acid, resulting in red or pink colonies, whereas non-lactose fermenters form colorless or pale colonies. The medium is suitable for routine microbiological analysis in food, pharmaceutical, environmental and clinical laboratories and complies with European Pharmacopoeia (EP), United States Pharmacopeia (USP) and ISO standards.
Advantages
- Selective inhibition of Gram-positive bacteria.
- Differentiation of lactose-fermenting and non-fermenting Gram-negative organisms.
- Compliant with EP, USP and ISO microbiological standards.
- Widely accepted medium for routine quality control and microbiological testing.
Technical specifications
| Pack size | 500 g |
| Standards / Compliance | EP / USP / ISO |
| Final pH (25 °C) | ≈ 7.1 ± 0.2 |
| Selective agents | Bile salts, crystal violet |
| Differential components | Lactose, neutral red |
| Typical incubation | 35–37 °C, 18–24 h, aerobic |
| Intended use | Isolation and differentiation of Enterobacteriaceae |
| Chemical type | Microbial Culture Media |
| Brand | Condalab |
| Pack size | 500 g |